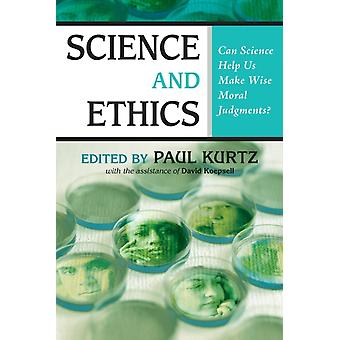

Société et Politique
Trouvez 464 298 société et politique aux meilleurs prix et rapport qualité-prix. Pour trouver des articles société et politique, rien de plus simple avec Fruugo et des REMISES, offres et économies sur les MicroConnect, AXIS - CAMERA, EPSON - BS LABEL CONSUMABLES U4 et d’autres marques. Achetez des articles société et politique en ligne et en toute sécurité avec Fruugo, tout en profitant de moyens de paiement sécurisé et de livraison rapide au France.
Filtres
463 873 - 463 904 sur 464 298